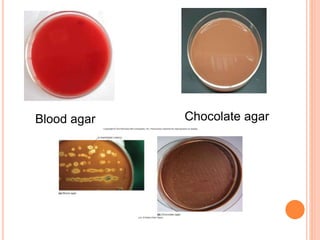
Blood agar Chocolate agar
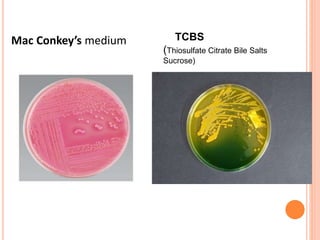
Mac Conkey’s medium TCBS
(Thiosulfate Citrate Bile Salts
Sucrose)
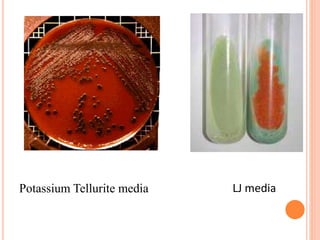
Potassium Tellurite media LJ media
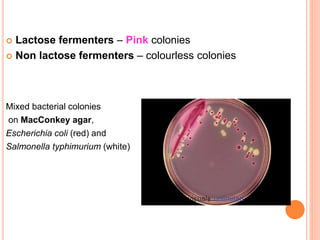
 Lactose fermenters – Pink colonies
 Non lactose fermenters – colourless colonies
Mixed bacterial colonies
on MacConkey agar,
Escherichia coli (red) and
Salmonella typhimurium (white)
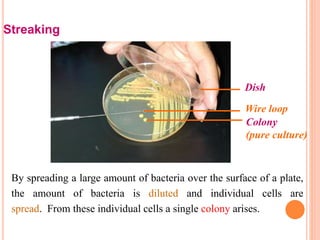
Streaking
By spreading a large amount of bacteria over the surface of a plate,
the amount of bacteria is diluted and individual cells are
spread. From these individual cells a single colony arises.
Wire loop
Dish
Colony
(pure culture)

This document discusses the physiology of microorganisms, including their growth, metabolism, and cultivation. It explains that bacteria multiply through binary fission, which allows populations to double within a set generation time. Growth occurs in distinct phases on a curve and is influenced by temperature, pH, oxygen levels, and other environmental factors. Metabolism involves both catabolism, through processes like respiration and fermentation, and anabolism to build cell structures. Microbes can be cultivated using culture media tailored to their physical and nutritional requirements.